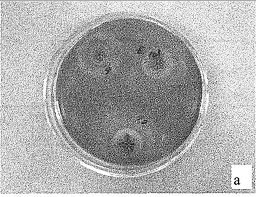

【作者】单丽君 郑晓冬 叶兴乾 詹喜
【机构】浙江大学生物系统工程与食品科学学院 浙江大学生物系统工程与食品科学学院 杭州310029
【摘要】本试验对14个菌株以柑橘皮为主要原料固体发酵生产复合酶的生产性能进行了比较, 发现宇佐美曲霉Aspergillus usaanii具有较好的复合酶产率,为进一步提高该菌株的产酶能力, 我们利用γ-射线辐射对其进行了诱变育种,选育得到一株纤维素酶活提高26%、酸性蛋白酶提高28%、木聚糖酶提高24.5%的突变菌株AU—C33。采用正交试验方法对该菌株的基础培养基进行了优化,结果表明豆粕和尿素含量对各酶活具有极显著影响。以柑橘粉计,当添加23% 豆粕、8%麸皮、3%尿素,水分含量在60%,28℃培养60h后,CMCase、FPA、β-葡萄糖苷酶、酸性蛋白酶和木聚糖酶分别达到了20.8U/g、7.25U/g、74.7U/g、7248.4U/g和3222.6U/g。
ManBetX体育宇佐美曲霉; γ-射线诱变; 突变菌株;
图Za初筛平板上生长的突变菌株水解圈直径/菌落直径二2.10
